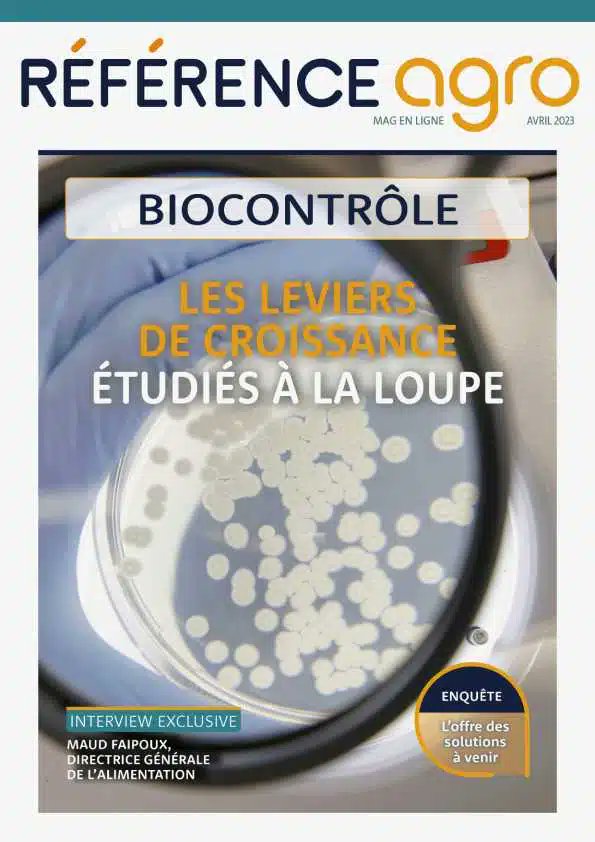
Référence agro tweet media

Sabitlenmiş Tweet

Les bacheliers ne sont pas les seuls à avoir parfois besoin de #rattrapage
Pour ceux qui les auraient ratés, nous avons ici deux beaux magazines en ligne sur Référence agro : spécial #bisotimulants et spécial #biocontrôle !

Français











